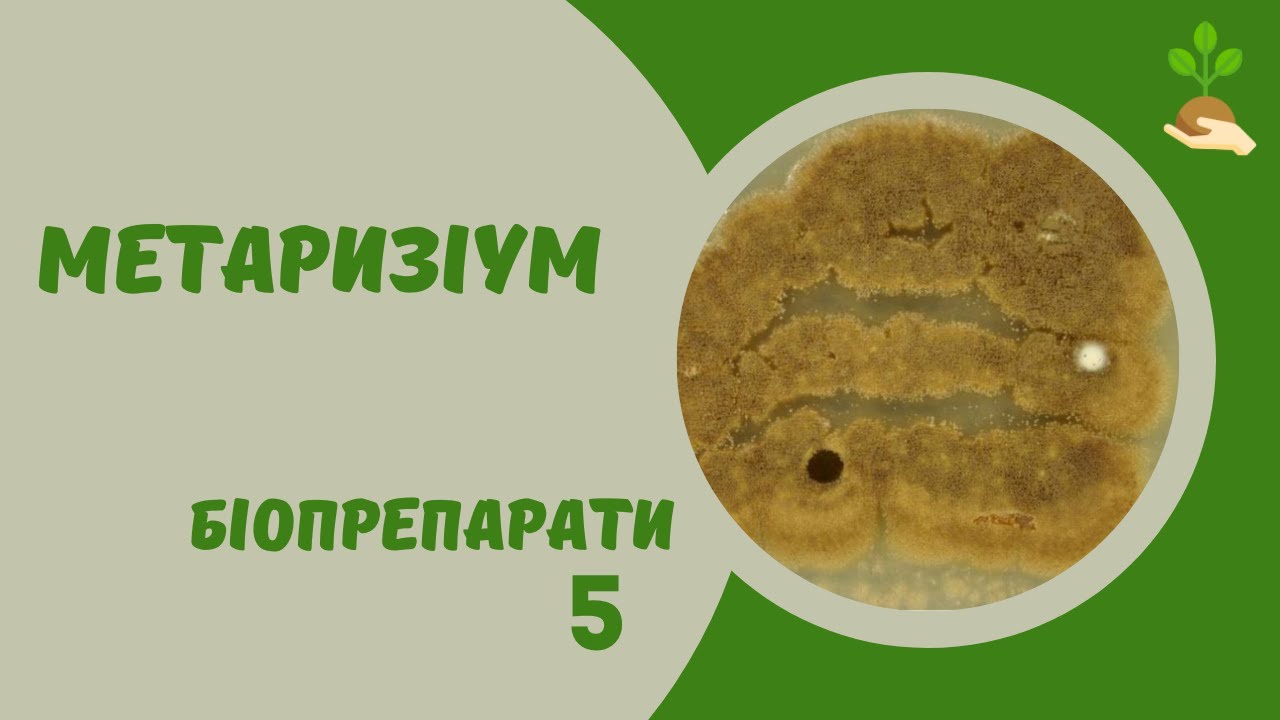

Як розводити метаризіум?
Як розводити препарат Максим?
Щоб отримати 1 л готової до використання рідини, треба розвести в 1 л води 2 мл препарату Максим®. Отриманий розчин використовують для замочування або обприскування цибулинних рослин. Не можна перевищувати дозування, зазначені в інструкції із застосування.
Як розвести Максим для орхідей?
4 мл Максима розводять у 2 л води, ретельно перемішують. Розчин витрачається з розрахунку 1 л розчину на 1 кг посадкового матеріалу. Для декоративних кімнатних рослин 5-6 крапель препарату розчиняють в 0,2 л води. Обробку Максимом проводять тільки 1 раз.
Скільки коштує Максим?
В наявності: 100+ шт. Товар в наявності! 219,00 грн.
Як пришвидшити ріст орхідеї?
Для повноцінного розвитку орхідеї необхідні такі ключові умови: По-перше, забезпечення правильного рівня вологості. По-друге, підтримка оптимальної температури повітря. По-третє, достатнє освітлення як для самої рослини, так і для її коріння (для орхідей зазвичай обирають прозорі пластикові або скляні горщики).
На присадибних ділянках використовувати 500-1000 мл на 10 л води на 2 сотки. Препарат найбільш ефективний проти личинок шкідників молодшого віку і при достатній …
Препарат розчиняють у водогінній воді, яка не містить хлору. Бак оприскувача наповнюють на 1/2 водою, потім при включеному змішувачі додають препарат. Після …
Метаризин М можна вносити в грунт будь-яким доступним способом: шляхом змішування з добривами, розчиненням в поливній воді, обприскуванням ґрунту. Найбільша …
Метаризіум – хижий грунтовий гриб. Він здатний зберігати і надавати м’який, багаторічний вплив на грунт, стримуючи своєю присутністю …
Метаризин М можна вносити в грунт будь-яким доступним способом: шляхом змішування з добривами, розчиненням в поливній воді, обприскуванням ґрунту. Найбільша …